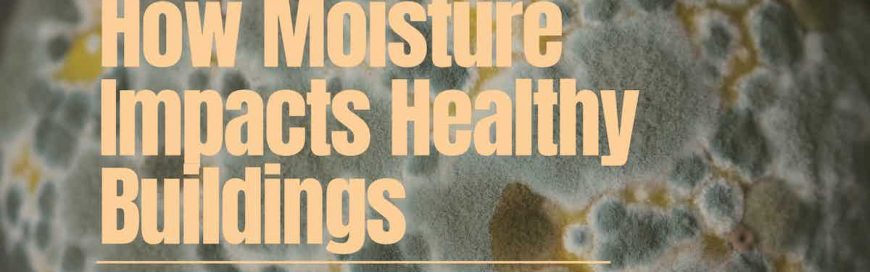
How Moisture Impacts Healthy Buildings

The health impacts of building dampness include respiratory problems and increased risk of infection, highlighting the need for preventive measures such as adequate ventilation, moisture control, and regular maintenance to reduce the risk of dampness-related health issues and structural damage.

Mold, Mildew, and Dampness in Public Buildings
Maintaining a healthy building requires moisture level regulation.
Insufficient moisture can lead to dryness of the nasal and respiratory systems, resulting in irritation.
In contrast, excessive moisture can lead to occupant health issues and damage to the built environment.
Studies show moisture in public buildings has been linked to respiratory illnesses, asthma, and allergies, and can contribute to the emergence of additional health hazards such as mold, cockroaches, dust mites, pathogens, and bacteria.
According to the American Lung Association;
Dampness creates the environment for mold to grow.
Dampness can cause harm even when mold is not present.
Excessive moisture also promotes the growth of dust mites, cockroaches, bacteria and viruses, which can impact health.
Exposure to mold can trigger allergic reactions and asthma symptoms in people who are allergic to mold.
However, even without mold, dampness indoors causes asthma attacks and other upper and lower respiratory problems.
Anyone—with or without allergies—may experience irritation of the eyes, skin, nose, throat and lungs when exposed to airborne mold particles.
The Burden of Illness in Damp Facilities
Until recently, relatively little scientific data existed supporting the direct connection between building dampness and occupant health issues.
According to the results of several meta-analyses published by the Indoor Air Quality Scientific Findings Resource Bank at Berkely Lab;
These meta-analyses have generally found increases in respiratory symptoms (e.g., cough, wheeze, allergic rhinitis) and asthma diagnosis associated with visible dampness and mold with odds ratios generally in the range of 1.4 to 1.8, implying roughly 40% to 80% increases in health outcomes in [buildings] with dampness and mold.
The meta-analyses include few statistically significant associations of health outcomes with levels of mold spores or with concentrations of chemical markers of mold.
The financial burden of excessive moisture in public facilities exceeds $20B annually.
A 2016 analysis estimated that the economic costs of indoor mold and related water dampness problems are about $22.4 billion.
These annual USA costs amount to $3.7 billion for allergic rhinitis, $1.9 billion for bronchitis, $15.1 billion for asthma morbidity and $1.7 billion for asthma mortality.
Many studies have reported that indoor control of water and mold problems can significantly reduce medical and lost productivity costs.
Economic Costs Of Indoor Molds- Estimated $22.4 Billion Us Annually
Causes and Sources of Moisture in Public Buildings
Mold and mildew require moisture to grow.
Moisture typically enters a building in one of four ways:
- Bulk Moisture - Water movement in large quantities, such as through pipes or channels. This type of movement is driven by pressure differences and can occur in both natural and engineered systems, such as groundwater flow and water distribution networks.
- Capillary Action -The ability of a liquid to flow in narrow spaces without the assistance of external forces, such as gravity. It occurs due to the combined forces of adhesion, which causes the liquid to cling to a surface, and cohesion, which causes the liquid to cling to itself.
- Air-Transported Moisture - The water vapor present in the atmosphere that can be transported by air currents. This moisture can contribute to weather patterns, precipitation, and the overall water cycle on Earth.
- Vapor Diffusion - The movement of water vapor through a material or medium, such as air or a solid substance. This process occurs due to differences in vapor pressure, with water vapor moving from higher to lower pressure areas.
Prevention and Remediation of Moisture, Mold, and Mildew
Moisture problems can arise from various sources, including outdoor and indoor issues.
To prevent and eliminate these issues, the source of the moisture should be controlled while ensuring adequate ventilation.
- Clean up spills immediately.
- Clean and sanitize occupied building spaces daily.
- Regularly clean and maintain rain gutters, ensuring that they drain away from the foundation of the building structure.
- Install and operate exhaust fans in the bathroom and kitchen or open windows for sufficient ventilation.
- Vent all fans and appliances to the outside of the facility.
- Do not place or store items such as furniture or storage boxes against the interior side of exterior walls.
- Repair plumbing leaks, roof leaks or problems, and cracks in foundation walls immediately.
- Ensure that soil and landscaping near the structure's foundation are graded away from the foundation.
- Install floor drains or sump pumps in basements as required.
- Maintain a comfortable indoor temperature, not excessively hot in the winter or cool in the summer, as drastic changes between indoor and outdoor temperatures can cause moisture issues.
- Verify indoor air quality through routine monitoring and testing.
In the event of a mold or mildew infestation:
- The first step is to address the source of the moisture.
- In the event of flooding, cleaning and drying the home thoroughly and quickly within 24-48 hours is crucial.
- Mud and dirt should be dug out, the remaining dirt vacuumed, and cleanable surfaces scrubbed with soapy water and a brush.
- Moldy items should be removed from living areas and replaced, as mold cannot be effectively cleaned from carpet, insulation, ceiling tiles, drywall, and wallboard.
- Commercial products, soap, water, or a bleach solution of no more than 1 cup of bleach in 1 gallon of water can clean mold from hard surfaces.
- Bleach should never be mixed with ammonia or other household cleaners.
- When using bleach, always wear non-porous gloves and protective eyewear, open windows and doors for fresh air, and follow manufacturer instructions.
- For larger areas, contacting a professional mold cleaner may be necessary.
References & Resources
- Moisture
- Building Science Introduction - Moisture Flow
- Mold Remediation in Schools and Commercial Buildings Guide: Chapter 2
- Basic Facts about Mold and Dampness
Takeaway
The presence of dampness in public buildings can result in respiratory issues and increased infection risks.
Adequate ventilation, moisture control, and regular maintenance are crucial in reducing the risk of dampness-related health problems and structural damage.
The cost of indoor mold and dampness-related issues is estimated to be around $22.4 billion annually in the US alone, with many studies suggesting that indoor control of water and mold problems can significantly reduce medical and productivity costs.
Prevention of moisture and mold requires identifying and controlling the source, ensuring adequate ventilation, and cleaning up spills promptly.
Onboarding and managing the requisite labor and material resources necessary to ensure the highest standards of cleanliness are achieved and maintained may prove cost-prohibitive for many organizations.
Outsourcing is a proven method for onboarding highly in-demand cleaning and sanitization services and experience for a fraction of the price of maintaining a similar service in-house.
If you would like more information regarding the effectiveness of high-performance infection prevention and control measures, or if you would like to schedule a free, no-obligation on-site assessment of your facility's custodial needs, contact us today for a free quote!
In Bakersfield, CA, call (661) 437-3253
In Fresno, CA, call (559) 206-1059
In Valencia, CA, or Santa Clarita, CA, call (661) 437-3253
In Palmdale, CA, or Lancaster, CA, call (661) 371-4756